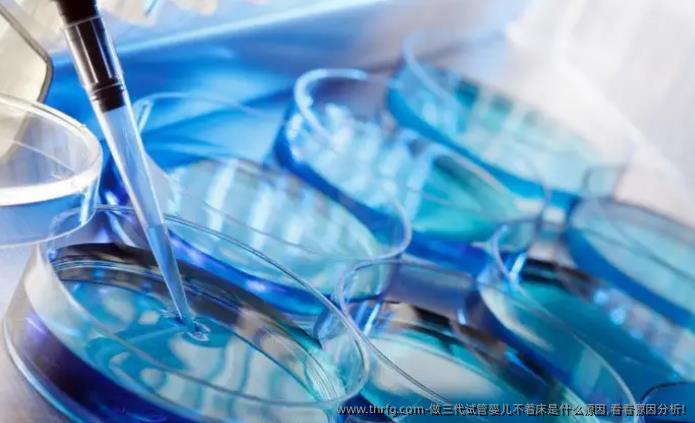
做三代试管婴儿不着床是什么原因,看看原因分析!

时间:2024-10-17 20:04:58
来源:泰国皇家生殖遗传医院(RFG医院)
三代试管婴儿技术,即胚胎植入前遗传学检测(PGT),是在体外受精(IVF)基础上发展起来的一项新技术。它通过筛选出健康的胚胎进行移植,从而提高妊娠成功率并降低遗传疾病风险。然而,在实际操作过程中,即便使用了这一先进技术,有时仍会出现胚胎不着床的情况。下面将从多个角度分析可能导致三代试管婴儿移植失败的原因:
染色体异常:尽管PGT技术能够筛查出染色体正常的胚胎,但并非所有异常都能被检测到。某些微小的基因突变或结构异常可能会影响胚胎发育及着床。
胚胎发育速度:胚胎在培养过程中的发育情况也是影响着床率的重要因素之一。发育过快或过慢都可能导致移植后不易着床。
子宫内膜状态:子宫内膜厚度、血流状况及是否存在炎症等问题都会影响胚胎着床。理想的子宫内膜厚度应在8mm以上,且需具备良好的血供环境。
免疫排斥反应:母体免疫系统对胚胎产生排异反应也会阻碍其正常着床。某些自身免疫性疾病患者更容易出现这种情况。
激素水平失衡:如雌激素与孕酮分泌不足或过多均会影响子宫内膜生长周期及胚胎着床条件。
卵泡取出过程损伤:过度刺激卵巢可能会导致卵子质量下降,而卵泡取出手术过程中若操作不当还可能对卵子造成一定损害。
实验室条件:胚胎培养环境如温度、湿度、气体成分等稍有偏差都可能影响其发育状态。
情绪波动:长期处于紧张焦虑状态下,不仅会影响女性体内激素分泌,还可能导致子宫收缩加剧,不利于胚胎稳定着床。
生活方式:吸烟、饮酒等不良习惯以及缺乏规律作息、高强度运动等都可能间接影响到整个辅助生殖治疗效果。
男性精子质量:虽然三代试管主要针对女性方面的问题,但如果男方精子存在严重质量问题,同样可能影响最终结果。
不明原因:即便排除了上述所有可能性,有时候仍然找不到明确的答案解释为何胚胎无法成功着床。这可能是由于个体差异或目前科学尚未完全掌握的因素所致。
面对三代试管婴儿不着床的情况,夫妻双方应保持积极心态,并与专业医生密切沟通,根据具体情况调整方案,尝试不同治疗方法。同时,注意改善生活习惯,减轻心理负担,为下一次尝试创造更好的条件。
上一篇: 泰国第三代试管婴儿优势、适应人群有哪些?
上一篇: 三代试管婴儿试管,时间是什么时候?
返回列表
推荐阅读

2025年商洛市可以做试管婴儿的医院有哪些?费用纳入医保了吗?
2025年,如果你在商洛市想了解哪些医院可以做试管婴儿,目前公开的信息显示,商洛市本地还没有具备试管婴儿技术资质的正规医疗机构。试管婴儿属于辅助生殖技术中的一种较高难度项目,通常需要具备“人类辅助生殖
2025-10-10 15:44:23
查看详情

2025年汉川市哪个医院做试管婴儿比较专业?做试管婴儿的流程安排是怎么样的?
2025年,如果你想在汉川市做试管婴儿,建议优先考虑当地规模较大、设备齐全、有妇产科和生殖医学中心的医院。一般来说,像汉川市人民医院这样的综合性医院,或者一些与武汉等地大型三甲医院有合作的医疗机构,可
2025-10-01 10:34:18
查看详情

养囊五天了还不知道结果说明没希望了吗?
养囊五天了,结果还没出来,心里肯定特别着急吧?其实这种情况挺常见的,很多人在做试管婴儿的时候都会经历类似的焦虑。养囊五天还没出结果,不代表就没有希望,咱们先别自己吓自己。首先,咱们得明白什么是“养囊”
2025-10-01 08:56:42
查看详情

江博士儿童鞋真的有那么好的矫正效果吗?
江博士儿童鞋在市面上宣传得比较多,尤其是针对儿童足部发育问题,比如扁平足、内八字等,声称有矫正效果。很多家长听到这些宣传后,都会想给孩子买一双试试看,毕竟谁不希望孩子走路姿势正常、脚长得健康呢?但话说
2025-10-01 07:18:00
查看详情

30岁女人为什么排卵期卵巢内没有卵泡?
30岁的女性在排卵期时,卵巢内没有卵泡,这种情况听起来确实让人担心。很多女性在备孕或关注自己身体状况时,都会特别在意卵泡的发育情况。如果在排卵期做B超检查,发现卵巢里没有卵泡,可能会让人疑惑:是不是不
2025-09-30 17:10:21
查看详情

2025年在石首市做试管婴儿去哪家医院比较好?石首市试管婴儿医院推荐
2025年在石首市做试管婴儿,很多夫妻可能会面临一个共同的问题:去哪家医院比较好?虽然石首市本身是湖北省荆州市下辖的一个县级市,医疗资源相对有限,但随着试管婴儿技术的普及,越来越多的夫妻开始关注这一领
2025-09-30 15:32:19
查看详情

宫颈lsil低级别病变影响试管移植吗?
宫颈LSIL(低级别鳞状上皮内病变)是宫颈细胞出现的一种轻度异常变化,通常和人乳头瘤病毒(HPV)感染有关。这种病变大多数情况下是良性的,有可能会自行恢复,但也需要定期随访观察。对于准备做试管婴儿移植
2025-10-14 23:17:27
查看详情

2025年彬州市能做第三代试管婴儿的医院有哪些?能用社保报销吗?
2025年,彬州市如果已经有能够开展第三代试管婴儿技术的医院,那一般会是当地规模较大、生殖医学中心较为成熟的三甲医院。不过,截至目前为止,彬州市的医疗资源在国内范围内来看还是相对有限的,特别是在辅助生
2025-10-10 19:02:02
查看详情

2025年在甘肃省做试管婴儿怎么样?大概要花多少钱?
2025年在甘肃省做试管婴儿,其实跟其他省份的情况差不多,但也会有一些地方性的差异。甘肃的医疗水平这些年也在不断提升,不少三甲医院都已经开展了试管婴儿技术。如果你打算在甘肃做试管婴儿,可以先了解一下当
2025-10-10 17:22:33
查看详情

2025年在莆田市做第三代试管婴儿推荐哪家医院?费用高吗?
2025年在莆田市做第三代试管婴儿,很多人会关心哪家医院靠谱,还有费用方面的问题。其实,莆田市本地的医疗资源在近几年也有一定的发展,但说到做试管婴儿,特别是第三代技术,还是得找有资质、经验丰富的医院。
2025-09-30 23:46:04
查看详情

为什么做三代试管更容易出现嵌合体囊胚?
在做试管婴儿的过程中,三代试管(也就是胚胎植入前遗传学检测,PGT)相比一代或二代试管,更容易出现“嵌合体囊胚”的情况。很多人听到“嵌合体”这个词可能会觉得有点陌生,其实它指的是胚胎中存在两种或更多不
2025-09-30 18:49:38
查看详情

2025年石嘴山市可以做试管婴儿的医院有哪些?费用纳入医保了吗?
2025年在石嘴山市,如果你有做试管婴儿的打算,可能需要先了解一下当地有哪些医院具备这方面的技术。目前来说,石嘴山市的医疗资源在不断改善,但能够开展试管婴儿技术的医院相对较少。一般来说,这类技术主要集
2025-09-30 07:18:00
查看详情
咨询热线
4000279913
客服微信

在线留言
返回顶部